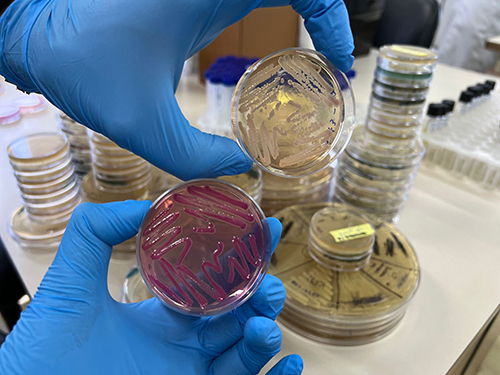

Claudia Jurberg
|
| Pesquisa liderada por pesquisadores do LNCC e Unifesp, com foco na descoberta e validação de novos antibióticos, foi pré-selecionada em maio entre mais de 800 submissões. Após diversas análises técnicas realizadas por especialistas da Fundação Gates, proposta foi oficialmente aprovada neste mês de outubro (Foto: Divulgação) |
Uma colaboração interdisciplinar liderada por pesquisadores do Laboratório Nacional de Computação Científica (LNCC/MCTI) e da Universidade Federal de São Paulo (Unifesp), em parceria com instituições do Brasil, México, Argentina, Uruguai, Chile, Portugal e Canadá, foi selecionada na prestigiada iniciativa internacional Global Grand Challenges – Gr-ADI (Gram-Negative Antibiotic Discovery Innovator).
Patrocinado pelas Fundações Gates, Wellcome e Novo Nordisk, o programa apoia esforços inovadores voltados ao desenvolvimento de novos antibióticos capazes de combater infecções causadas por bactérias gram-negativas resistentes, consideradas uma das maiores ameaças à saúde pública global.
A pesquisadora do LNCC e líder da iniciativa, Marisa Fabiana Nicolás, explica que a proposta brasileira intitulada “Translational Approach with AI for Klebsiella Drug Discovery” foi pré-selecionada em maio de 2025 entre mais de 800 submissões e, após diversas análises técnicas realizadas por especialistas da Fundação Gates, foi oficialmente aprovada em outubro de 2025.
"Nossa iniciativa passa agora a integrar o consórcio global como um dos projetos finalistas e receberá financiamento significativo por 36 meses, com foco na descoberta e validação de novos antibióticos, especialmente contra Klebsiella pneumoniae", conta Nicolás.
Ela explica que essa bactéria é responsável por diversas infecções graves, como pneumonias, infecções de corrente sanguínea e urinárias e abscessos hepáticos, cujo tratamento tem se tornado cada vez mais difícil diante do aumento alarmante da resistência aos antibióticos disponíveis, incluindo os novos inibidores de betalactamases.
"A resistência aos antimicrobianos representa um problema de saúde pública mundial. Foi estimado que aproximadamente 4,95 milhões de mortes em todo o mundo foram associadas a infecções causadas por bactérias resistentes, sendo que 1,27 milhão foram diretamente atribuídas a essas infecções. Projeções indicam que, até 2050, o número de mortes diretamente atribuídas à resistência aos antimicrobianos poderá ultrapassar 1,9 milhão, enquanto as mortes associadas poderão alcançar 8,2 milhões, com impacto particularmente acentuado entre idosos", ela explica.
A Klebsiella pneumoniae resistente às cefalosporinas de terceira e quarta gerações ou carbapenêmicos tem sido reconhecida pela Organização Mundial da Saúde (OMS) como um dos patógenos de prioridade crítica para receber os investimentos em pesquisa e desenvolvimento de novos antibióticos, vacinas, diagnósticos e tratamentos, já que essa bactéria têm se tornado resistentes a todos os antimicrobianos disponíveis para uso clínico.
O pesquisador Laurent Dardenne, também do LNCC, conta que o projeto terá início em dezembro de 2025 e está estruturado em quatro fases principais. Inicialmente, a priorização de alvos terapêuticos. Em seguida, a validação funcional e genética. Posteriormente, ele explica que os pesquisadores envolvidos na rede se dedicarão a descoberta de compostos ativos e, por fim, haverá a etapa de validação experimental de substâncias ativas contra os alvos selecionados.
"Importante ressaltar que toda a base estrutural e científica deste projeto contou com o apoio e financiamento de importantes agências nacionais de fomento como a FAPERJ, a Fapesp, Capes e o CNPq. Sem esse financiamento, não teríamos conquistado esse grant da Fundação Gates", ressalta Dardenne.
Inteligência artificial e supercomputação
O projeto tem como objetivo identificar e validar novos alvos terapêuticos e obter ao menos uma molécula com ação comprovada sobre um ou dois desses alvos, com potencial terapêutico contra K. pneumoniae.
Para isso, integra abordagens computacionais de última geração – como inteligência artificial (IA), modelagem molecular, bioinformática e triagem virtual – com validação experimental por meio de ensaios biológicos. Essas análises exigem grande capacidade de processamento, viabilizada pelo uso do Supercomputador Santos Dumont (SDumont), instalado no LNCC, o mais potente da América Latina dedicado à pesquisa científica.
Um dos pilares tecnológicos do projeto será a aplicação de modelos de inteligência artificial generativa, desenvolvidos no próprio LNCC. Esses modelos utilizam uma abordagem de novo multiobjetivo, capaz de propor novas moléculas potencialmente ativas contra alvos moleculares a serem validadas experimentalmente ao longo do projeto.
Essas metodologias fazem parte do ecossistema de programas DockThor-VS (https://www.dockthor.lncc.br), DockTDesign e DockTDeep, desenvolvidos pelo Grupo de Modelagem Molecular de Sistemas Biológicos do LNCC.
 |
| Laurent Dardenne e Marisa Fabiana Nicolás, pesquisadores no LNCC: proposta de estudo pré- aprovada se apoia na integração de múltiplas abordagens inovadoras, combinando metodologias computacionais e experimentais de última geração, incluindo aplicação de ferramentas avançadas de inteligência artificial, aprendizado de máquina e modelagem molecular (Foto: Divulgação) |
"O portal DockThor-VS, integrado ao supercomputador SDumont, é hoje uma das principais plataformas globais de triagem virtual em larga escala. Somente nos últimos dois anos, mais de 40 mil simulações foram submetidas por pesquisadores de diversos países, evidenciando seu impacto e sua relevância internacional na descoberta de fármacos assistida por supercomputação", explica Dardenne.
Grandes diferenciais
Entre os principais diferenciais desta proposta está a sólida colaboração entre o Labinfo/LNCC e o Instituto Paulista de Resistência aos Antimicrobianos (ARIES) da Universidade Federal de São Paulo (Unifesp), uma das maiores referências em resistência antimicrobiana no Brasil e no cenário internacional.
"Juntas, as equipes conduziram o sequenciamento e a análise de um dos primeiros genomas completos de um isolado de K. pneumoniae produtor da carbapenemase KPC, que, além de resistente aos antibióticos carbapenêmicos, também era resistente às polimixinas - a última opção terapêutica disponível naquela época. Essa colaboração, somada a estudos clínicos e epidemiológicos de resistência, fortalece a base translacional do projeto", explica Nicolás.
Os pesquisadores ressaltam que a proposta se apoia na integração de múltiplas abordagens inovadoras, combinando metodologias computacionais e experimentais de última geração. No eixo in silico, serão aplicadas ferramentas avançadas de inteligência artificial, aprendizado de máquina e modelagem molecular. Além disso, a pesquisa será reforçada pelo protocolo desenvolvido pelo grupo argentino Target Pathogen, em colaboração com especialistas da Fiocruz (BA), México, Uruguai e Chile.
Do ponto de vista experimental, o projeto contará com tecnologias de ponta como CRISPR interference (CRISPRi) – uma técnica de silenciamento genético que permite inibir genes específicos para estudar sua função –, e Ribo-seq, um método que analisa quais proteínas estão sendo produzidas pelas bactérias em condições de estresse. Também serão realizados ensaios funcionais de expressão e inibição enzimática, de avaliações de concentração inibitória mínima, toxicidade e cristalografia de alguns alvos moleculares com compostos antimicrobianos promissores.
As etapas de síntese, otimização e testes microbiológicos serão conduzidas por grupos com experiência consolidada da UFRJ, da Unifesp e da Universidade de Manitoba do Canadá.
Essa integração entre diferentes frentes tecnológicas permitirá validar biologicamente os alvos identificados e comprovar, in vitro e in vivo, a eficácia das substâncias promissoras encontradas sobre os alvos validados.
Um passo para antibióticos de nova geração
A combinação entre priorização de novos alvos moleculares associada ao planejamento de novas moléculas por meio de IA generativa apoiada pela validação experimental é a chave para o desenvolvimento de antibióticos de nova geração.
"Ser selecionado em uma concorrência internacional altamente competitiva, na qual a inovação científica foi um dos critérios centrais, reforça a relevância e a excelência da ciência brasileira e latino-americana em uma área de pesquisa considerada extremamente desafiadora e com potencial de beneficiar milhões de pessoas em todo o mundo", ressalta Nicolás.
Os pesquisadores destacam que este projeto tem a colaboração de uma equipe multidisciplinar brasileira e internacional e conta com a colaboração de Isabela Alvim Guedes, Fabio Custódio, André Borges Farias e Maria Carolina del Valle Sisco Zerpa, do LNCC; Lídia Moreira Lima da UFRJ; Ana Cristina Gales, Fernanda Fernandes dos Santos e Marcelo Ferreira Marcondes Machado, da Unifesp; Pablo Ivan Pereira Ramos da Fiocruz Bahia; Priscilla Capriles da Universidade Federal de Juiz de Fora; Adrian Turjanski e Dario Fernandez Do Porto da Facultad de Ciencias Exáctas y Naturales (FCEyN) da Universidade de Buenos Aires (Argentina); Pablo Smircich e José Sotelo da Universidad de la República (Udelar) e Instituto Clemente Estable (Uruguai); Ernesto Pérez Rueda da Universidad Nacional Autónoma de Méxic (México); J. Eduardo Martinez-Hernandez da Universidad de las Américas (Chile); Silvia Cardona da University of Manitoba do Canadá; Pedro J. B. Pereira da i3S – Universidade do Porto (Portugal).